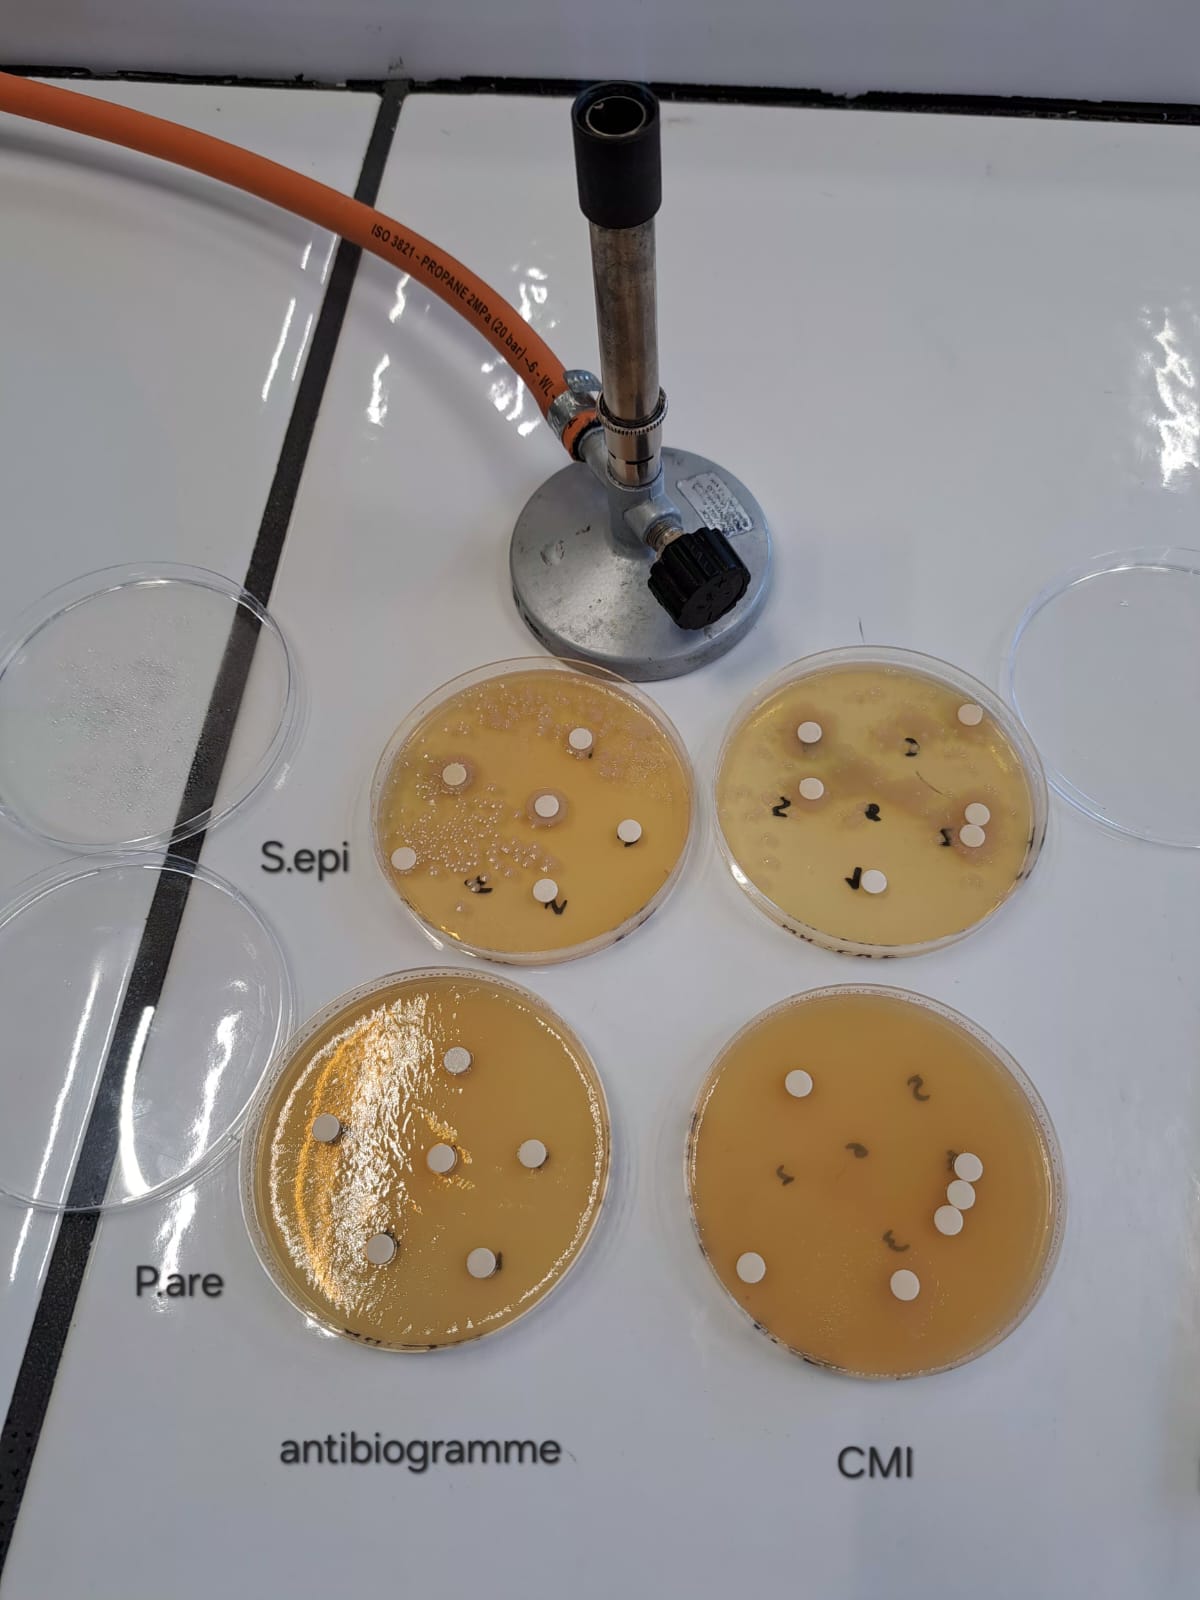
Lecture finale des résultats

La Composition du Parfum
Un parfum est un mélange complexe d'alcool, de molécules odorantes, de fixateurs et de conservateurs.
Alcool
Solvant principal (éthanol). Dénaturant, évaporation rapide.
Molécules parfumantes
Linalool, limonène, aldéhydes, esters — responsables de l'odeur.
Fixateurs
Benzyl benzoate, musc — prolongent la tenue.
Conservateurs
BHT, antioxydants — stabilité du produit.
Formule développée — Éthanol
L'Éthanol, solvant principal
Solvant amphiphile
Dissout les molécules aromatiques apolaires (terpènes) grâce à sa nature à la fois polaire et apolaire.
Action dénaturante
Perturbe les protéines membranaires bactériennes par dénaturation. Efficacité maximale ~70 % v/v.
Effet dose-dépendant
L'activité antimicrobienne diminue avec la dilution — principe fondateur de l'étude CMI.
8 composants testés au laboratoire

Nos réactifs purs
Linalool (Lina.l C₁₀H₁₈O) · Limonène · Éthanol absolu 99.8 %